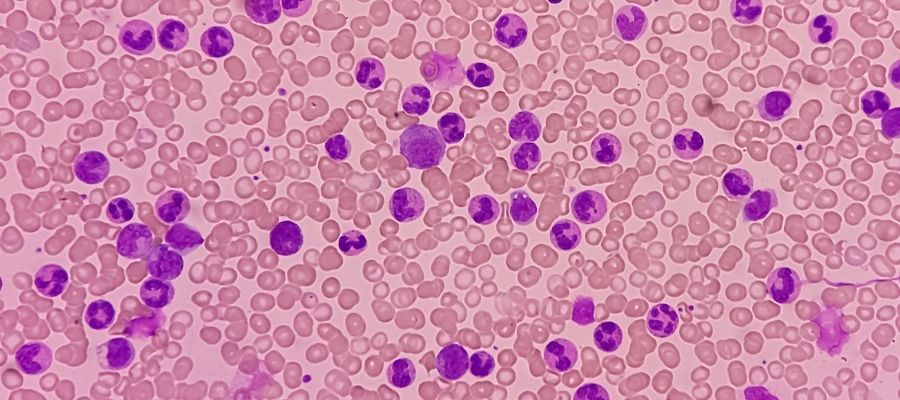

KML, kemik iliğinde üretilen beyaz kan hücrelerinin anormal seviyelerde oluşuyla karakterize edilen bir kanserdir. Genellikle belirgin bir semptom göstermeyen bu hastalık zamanla halsizlik, gece terlemeleri ve kilo kaybı gibi belirtiler sonucu ortaya çıkabilir. KML, hücrelerdeki genetik bir değişiklik sonucu yaşanır.
Tanı, kan testlerine ek olarak kemik iliği biyopsisiyle konur. Tedavi seçenekleri içinde ilaç kullanımı, hedefe yönelik tedavi ve kemoterapi bulunur. Erken teşhis ile tedaviye başlamak, hastalığın yönetilmesinde önemlidir.
KML (Kronik Miyeloid Lösemi) Nedir?
Kronik miyeloid lösemi, kan yapımından sorumlu kök hücrelerin genetik değişime uğramasıyla ortaya çıkan bir hastalıktır. Bu değişim, Philadelphia kromozomu olarak bilinen anormal bir kromozomun oluşumuna yol açar. KML genellikle ileri yaşlarda görülür ve erkeklerde kadınlara kıyasla biraz daha sık rastlanır.
Hastalık kronik, hızlanan ve blastik kriz olmak üzere üç evrede ilerler. Klinik seyri kişiden kişiye değişiklik gösterirken bazı hastalarda uzun süre belirti vermeyebilir.
KML'nin Nedenleri ve Risk Faktörleri
KML'nin gelişiminde genetik değişiklikler temel rol oynar. Özellikle Philadelphia adı verilen anormal bir kromozomun varlığı hastalığın başlıca nedenleri arasında yer alır. KML’nin nedenleri şu şekilde sıralanabilir:
- Philadelphia kromozomu ve bcr-abl geni
- Genetik ve çevresel etkenler
- Radyasyon maruziyeti
- Yaş ile cinsiyetin etkisi
Bu etkenler, hastalığın ortaya çıkma riskini artırabilir. Ancak KML, bu faktörlerin bir veya birkaçının bir araya gelmesiyle de gelişebilir.
Philadelphia Kromozomu ve BCR-ABL Geni
Philadelphia kromozomu KML'nin oluşumunda kilit rol oynayan genetik bir anormalliktir. Bu durum, 9. ve 22. kromozomlar arasında gerçekleşen yer değişimi ile oluşur. Ortaya çıkan bu değişim, hücrelerde BCR-ABL adıyla bilinen anormal bir genin oluşmasına neden olur.
BCR-ABL geni, hücrelerin kontrolsüz bir şekilde çoğalmasına yol açan sürekli aktif bir tirozin kinaz enzimi üretir. Bu durum, sağlıklı kan hücrelerinin yerini anormal hücrelerin almasına neden olur. Philadelphia kromozomu, KML tanısında belirleyici bir bulgudur ve hedefe yönelik tedavilerin temelini oluşturur.
Genetik ve Çevresel Etkenler
KML'nin gelişiminde genetik ve çevresel faktörler beraber rol alır. Miyeloid hücreler, genetik mutasyonların kontrolsüz çoğalmasına neden olurken çevresel faktörler de bu süreci tetikleyebilir. Genetik yatkınlık ile çevresel maruziyetin birleşimi, hastalığın ortaya çıkma olasılığını artırabilir.
Radyasyon Maruziyeti
İyonlaştırıcı radyasyona uzun süre maruz kalmak, KML gelişimi için önemli bir risk faktörüdür. Kemik iliği hastalığı bu tür maruziyetlerin yol açabileceği genetik değişikliklere neden olabilir. Radyasyonun, hücrelerin DNA yapısını bozarak kontrolsüz büyümelerine yol açtığı düşünülmektedir.
Yaş ve Cinsiyetin Etkisi
KML genellikle 50 yaş ve üzeri bireylerde görece sık rastlanan bir hastalıktır. Erkekler, kadınlara oranla bu hastalığa daha yatkındır. Yaşın ilerlemesi ile cinsiyet, hastalığın gelişme sıklığını etkileyen önemli faktörlerdir.
KML'nin Belirtileri Nelerdir?
KML'nin belirtileri yavaş gelişir ve hastalar çoğu zaman bu semptomları normal yorgunluk veya stresle ilişkilendirir. Ancak hastalık ilerledikçe daha ciddi belirtiler meydana gelebilir. KML'nin belirtileri şu şekilde sıralanabilir:
- Yorgunluk ile halsizlik
- Kilo kaybı ve iştahsızlık
- Gece terlemeleri
- Dalak büyümesi (splenomegali)
- Sık enfeksiyon geçirme
Belirtileri zaman içinde farklı şiddetlere ulaşarak hastalığın evresine bağlı olarak değişir. Erken dönemde belirtilerin fark edilmesi, tedavi seçeneklerinin geniş olması açısından büyük önem taşır.
Yorgunluk ve Halsizlik
Yorgunluk ve halsizlik , KML hastalarında en yaygın görülen belirtilerden biridir. Bu durum, vücudun yeterli sayıda sağlıklı kan hücresi üretememesi nedeniyle ortaya çıkar. Aynı zamanda hastaların günlük aktivitelerini zorlaştırarak yaşam kalitesini önemli ölçüde etkileyebilir.
Kilo Kaybı ve İştahsızlık
KML hastalığında kilo kaybı, genellikle iştahsızlıkla birlikte görülür. Vücut, anormal hücrelerin aşırı üretimiyle mücadele ederken bu da normal beslenmeyi zorlaştırabilir.
Gece Terlemeleri
KML'nin ilerleyen evrelerinde gece terlemesi sıkça görülen belirtidir. Hastalar, geceleri aşırı terlemeye bağlı olarak sık uyanabilir ve rahatsızlık hissedebilirler. Gece terlemesi, vücudun enfeksiyonla savaşmaya çalıştığının göstergesi olabilir.
Dalak Büyümesi (Splenomegali)
Dalak büyümesi (splenomegali) KML'nin belirgin bir belirtisi olarak ortaya çıkar. Dalak, anormal kan hücrelerinin birikmesi nedeniyle büyüyebilir ve karın bölgesinde ağrıya ya da şişkinliğe neden olabilir. Bu durum, genellikle KML'nin ilerleyen evrelerinde daha belirgin hale gelir.
Sık Enfeksiyon Geçirme
KML hastalarında bağışıklık sistemi zayıfladığı için sık sık enfeksiyonlar görülebilir. Enfeksiyon, genellikle vücudun yeterince güçlü savunma gösterememesi nedeniyle hızla gelişebilir. Bu durum, hastaların iyileşme sürecini daha da zorlaştırabilir.
KML Nasıl Teşhis Edilir?
Philadelphia kromozomu varlığı, hastalığın kesin tanısının konmasında en belirleyici faktördür. Teşhisinde kullanılan yöntemler şunlardır:
- Tam kan sayımı ve diğer kan testleri
- Kemik iliği aspirasyonu veya biyopsisi
- Genetik testler ile moleküler analizler
Erken teşhis, tedavi sürecinin başarısını artırır ve hastalığın ilerlemesini engellemeye yardımcı olabilir.
Tam Kan Sayımı ve Diğer Kan Testleri
Kan testleri (tam kan sayımı) KML'nin teşhisinde ilk adımdır ve hastaların genel sağlık durumunu değerlendirmek için yapılır. Bu test, kanın temel bileşenlerinin sayımını yaparak olası anormallikleri belirler. Ayrıca beyaz kan hücrelerinin sayısındaki artışı da gözler önüne serer.
Beyaz kan hücreleri artışı, hastalığın en belirgin semptomlarındandır. Tam kan sayımı, hemoglobin seviyelerini kontrol ederek anemi varlığını da ortaya çıkarabilir. Tedavi süreci boyunca bu testler, hastalığın ilerlemesini izlemek için düzenli olarak yapılır.
Kemik İliği Aspirasyonu ve Biyopsisi
Kemik iliği biyopsisi, hastalığın ilerlemesini anlamak için yapılır. Bu işlem sırasında kemik iliğinden küçük bir örnek alınarak incelenir ve anormal hücrelerin varlığı araştırılır. Kemik iliği biyopsisi, hastalığın hangi evrede olduğunu belirlemeye yardımcı olarak tedaviye yön vermede kullanılır.
Genetik Testler ve Moleküler Analizler
Genetik testler, Philadelphia kromozomunun varlığını tespit etmek bakımından gerçekleştirilir. Bu testler, BCR-ABL geninin varlığını doğrulamak bakımından için kullanılarak tedavi sürecine yön verir. Hematoloji uzmanı, genetik test sonuçlarını değerlendirerek en uygun tedavi planını oluşturur.

KML'nin Evreleri Nelerdir?
KML kronik, hızlanan ve blastik evreler olarak üç farklı aşamada gelişir. Her evre, hastalığın seyrine göre klinik özellikler ile tedavi gereksinimlerinde değişiklikler gösterir. Hastalığın evreleri, tedavi planlarının belirlenmesinde kritik rol oynar.
Kronik Faz
İlk evre olan kronik faz, hastalığın başlangıç dönemi olup çoğu zaman belirgin semptomlar göstermez. Bu evrede hastalar tedaviye iyi yanıt verir ve yaşam kalitesi bozulmaz. Kan testlerinde beyaz kan hücrelerinin sayısında artış görülebilir ancak hastalık genellikle kontrol altındadır.
İleri (Akselere) Faz
İleri (akselere) faz sırasında hastalık, hızlı ilerlemeye başlayarak tedaviye daha az yanıt verir. Hücreler, kontrolsüz şekilde çoğalmaya devam eder ve semptomlar şiddetlenir. Bu evre, hastalığın daha karmaşık hale geldiği veya müdahale gereksinimlerinin arttığı dönemi ifade eder.
Blastik Kriz (Akut Faz)
Blastik kriz (akut faz) en ileri evre olup akut lösemiye dönüşüm olarak kabul edilir. Bu evrede, kan hücrelerinin çoğu anormal hale gelir ve hastalık hızla ilerler. Tedaviye dirençli hale gelen blastik kriz, acil tıbbi müdahale gerektiren bir durumdur.
KML Tedavi Yöntemleri Nelerdir?
KML tedavisi, hastalığın evresine ve hastanın genel sağlık durumuna bağlı olarak farklılık gösterebilir. Başlıca tedavi yöntemleri ise şu şekilde sıralanabilir:
- Tirozin kinaz inhibitörleri (TKI) tedavisi
- Kök hücre nakli
- Destekleyici tedaviler
- Tedavi sürecinde dikkat edilmesi gerekenler
Tedavi süreci, hastalığın kontrol altında tutulmasını sağlamayı hedefler ve her hasta için özelleştirilmiş bir plan oluşturulur. Düzenli izlem ile tedaviye uyum, hastalığın yönetilmesinde önemli rol oynar.
Tirozin Kinaz İnhibitörleri (TKI) Tedavisi
Tirozin kinaz inhibitörleri (TKI) KML tedavisinde en yaygın kullanılan ilaçlardır ve genetik mutasyonu hedef alarak hücrelerin büyümesini engeller. Bu tedavi, hastalığın seyrini yavaşlatarak hastaların yaşam kalitesini iyileştirebilir. TKI tedavisi, ilk seçenek olarak tercih edilerek hastalığın kronik fazda kontrol altında tutulmasına yardımcı olur.
Kök Hücre Nakli (Kemik İliği Nakli)
Kök hücre nakli, tedavilere yanıt vermeyen hastalar için başvurulan ileri tedavi seçeneğidir. Bu işlem, hastanın sağlıklı kök hücrelerle donatılmasını sağlar. Kök hücre nakli, hastalığın kalıcı olarak tedavi edilmesini hedefler. Doğru biçimde yürütülen operasyonlar sayesinde başarılı sonuçlar elde edilir.
Destekleyici Tedaviler
Destekleyici tedaviler, KML hastalarının genel sağlığını iyileştirmeye yönelik uygulamalardır. Hedefe yönelik tedav i, hastaların bağışıklık sistemi güçlendirilerek tedavi sürecine katkı sağlar. Bu sayede tedavi sürecinde yaşanabilecek olumsuzlukların da önüne geçilebilir.
Tedavi Sürecinde Dikkat Edilmesi Gerekenler
KML tedavi sürecinde düzenli uyum ile kontroller oldukça önemlidir. İlaçların yan etkileri izlenmeli ve gerektiğinde tedavi planı gözden geçirilmelidir. Ayrıca psikolojik destek ile yaşam tarzı değişiklikleri, hastaların tedavi sürecini kolaylaştırabilir. Bunun sonucu olarak da tedavi sürecinde başarılı sonuçlar alma olasılığında artış görülür.
KML ile Yaşam ve Öneriler
KML ile yaşam, hastalığın tedaviye yanıtına bağlı olarak değişiklik gösterebilir. Düzenli kontroller ile tedaviye sadık kalmak, hastalığın yönetilmesinde önemli rol oynar. Sağlıklı beslenme, egzersiz ile psikolojik destek, tedavi sürecini kolaylaştırarak yaşam kalitesini artırabilir.
Düzenli Takip ve Kontroller
KML tedavisinde düzenli kontroller, hastalığın ilerlemesini izlemek ve tedaviye alınan cevabı gözlemlemek bakımından kritik öneme sahiptir. Kan kanseri gibi ciddi bir hastalıkta erken dönemde tespit edilen herhangi bir değişiklik, tedavi sürecini olumlu yönde etkileyebilir. Bu nedenle hastaların tedaviye uyumu ile doktor kontrollerine düzenli gitmesi, uzun vadeli sağlık için oldukça önemlidir.
Tedavi Yan Etkileri ile Baş Etme
Tedavi yan etkileri hastalar için zorlu bir süreç olabilir. Bu yan etkilerle baş etmek için doktorlar, hastaların durumlarına özel öneriler sunarak semptomları hafifletmeye çalışırlar. Böylece sürecin daha sağlıklı bir biçimde takip edilmesi de desteklenmiş olur.
Sağlıklı Yaşam Tarzı Önerileri
KML tedavisi gören hastaların iyileşme süreci açısından olumlu katkı sağlayan öneriler bulunur. Doktorlar tarafından sunulan önerilerde uyku rutini ve beslenme düzeni gibi değişiklikler yer alır. Bu tarz bir yaşam, tedavi sürecinde hastaların genel sağlığını iyileştirebilir. Sağlıklı yaşam tarzı önerileri şunlardır:
- Dengeli ve besleyici bir diyet
- Rutin egzersiz
- Stres yönetimi
- Yeterli uyku ve dinlenme
- Düzenli doktor kontrollerine gitmek
Bu alışkanlıklar, tedaviye uyumu artırarak hastaların yaşam kalitesini iyileştirir. Ayrıca psikolojik destek de sürecin sağlıklı biçimde ilerlemesini sağlar. Psikolojik destek almak, hastanın sosyal yaşamına ve motivasyon düzeyine olumlu katkıda bulunur.
KML (Kronik Miyeloid Lösemi) Hakkında Sıkça Sorulan Sorular
KML (Kronik Miyeloid Lösemi) Nedir?
Kemik iliğinde anormal yapıdaki beyaz kan hücrelerinin üretimi sonucu oluşan kan kanseri türüdür. Bu hastalık, Philadelphia kromozomunun varlığıyla ilişkilidir ve genetik mutasyon sonucu gelişir.
KML Belirtileri Nelerdir?
KML'nin başlıca belirtileri arasında yorgunluk, kilo kaybı ve dalak büyümesi yer alır. Ayrıca bazı hastalarda gece terlemeleri ile halsizlik de görülebilir.
KML Neden Oluşur?
KML'nin oluşumunda, genetik bir mutasyon sonucu Philadelphia kromozomunun oluşması etkili olur. Bu kromozom, hücrelerin kontrolsüz şekilde büyümesine neden olan BCR-ABL genini içerir.
KML Nasıl Teşhis Edilir?
KML teşhisi, kan testleri, genetik analizler ve kemik iliği biyopsisi ile konur. Philadelphia kromozomunun varlığı, bu hastalığın tanısında belirleyici rol oynar.
KML Hangi Yaşlarda Sık Görülür?
Genellikle yetişkinlerde, özellikle 50 yaş ve üzeri bireylerde daha yaygın görülür. Ancak nadir durumlarda çocuklarda da görülebilir.
KML Tedavisi Mümkün müdür?
Tedavisi mümkündür ve genellikle Tirozin Kinaz İnhibitörleri (TKI) ile yapılır. Tedavi, hastalığın evresi ile tedaviye yanıtına göre şekillenir.
KML'de Kök Hücre Nakli Şart mıdır?
Kök hücre nakli diğer tedavilere yanıt vermeyen ileri evre KML hastaları için bir seçenek olarak değerlendirilir. Ancak her hastaya kök hücre nakli önerilmez, tedavi planı kişiye özel hazırlanır.
KML Hastaları Nelere Dikkat Etmelidir?
KML hastaları, düzenli doktor kontrollerine gitmeli ve tedaviye tam uyum sağlamalıdır. Ayrıca sağlıklı yaşam tarzı alışkanlıkları, tedavi sürecini destekler.
KML Tamamen İyileşir mi?
Tamamen iyileştirilemeyen bir hastalık olsa da, tedavi ile uzun süreli remisyon sağlanabilir. İyi bir tedavi ve düzenli takip ile hastalık kontrol altına alınabilir.
KML Genetik midir?
Evet, genetik hastalıktır ve genellikle Philadelphia kromozomunun oluşumu ile bağlantılıdır. Bu genetik değişiklik, hastalığın gelişimine yol açar.
Doktorlar
-
![Prof.Dr. AHMET ÖZTÜRK]() Prof.Dr. AHMET ÖZTÜRK
KML (Kronik Miyeloid Lösemi)
Prof.Dr. AHMET ÖZTÜRK
KML (Kronik Miyeloid Lösemi)
Hızlı Randevu Al
-
![Prof.Dr. AYŞEN TİMURAĞAOĞLU]() Prof.Dr. AYŞEN TİMURAĞAOĞLU
KML (Kronik Miyeloid Lösemi)
Prof.Dr. AYŞEN TİMURAĞAOĞLU
KML (Kronik Miyeloid Lösemi)
Hızlı Randevu Al
-
![Prof.Dr. İSMET AYDOĞDU]() Prof.Dr. İSMET AYDOĞDU
KML (Kronik Miyeloid Lösemi)
Prof.Dr. İSMET AYDOĞDU
KML (Kronik Miyeloid Lösemi)
Hızlı Randevu Al
-
![Prof.Dr. MUSTAFA ÇETİNER]() Prof.Dr. MUSTAFA ÇETİNER
KML (Kronik Miyeloid Lösemi)
Prof.Dr. MUSTAFA ÇETİNER
KML (Kronik Miyeloid Lösemi)
Hızlı Randevu Al
-
![Prof.Dr. S. SAMİ KARTI]() Prof.Dr. S. SAMİ KARTI
KML (Kronik Miyeloid Lösemi)
Prof.Dr. S. SAMİ KARTI
KML (Kronik Miyeloid Lösemi)
Hızlı Randevu Al
-
![Prof.Dr. SİRET RATİP]() Prof.Dr. SİRET RATİP
KML (Kronik Miyeloid Lösemi)
Prof.Dr. SİRET RATİP
KML (Kronik Miyeloid Lösemi)
Hızlı Randevu Al
-
![Prof.Dr. SONER SOLMAZ]() Prof.Dr. SONER SOLMAZ
KML (Kronik Miyeloid Lösemi)
Prof.Dr. SONER SOLMAZ
KML (Kronik Miyeloid Lösemi)
Hızlı Randevu Al
-
![Prof.Dr. TÜLİN TUĞLULAR]() Prof.Dr. TÜLİN TUĞLULAR
KML (Kronik Miyeloid Lösemi)
Prof.Dr. TÜLİN TUĞLULAR
KML (Kronik Miyeloid Lösemi)
Hızlı Randevu Al
-
![Dr. ANT UZAY]() Dr. ANT UZAY
KML (Kronik Miyeloid Lösemi)
Dr. ANT UZAY
KML (Kronik Miyeloid Lösemi)
Hızlı Randevu Al
-
![Dr. EBRU ERDOĞAN]() Dr. EBRU ERDOĞAN
KML (Kronik Miyeloid Lösemi)
Dr. EBRU ERDOĞAN
KML (Kronik Miyeloid Lösemi)
Hızlı Randevu Al
-
![Dr. SELİN BERK]() Dr. SELİN BERK
KML (Kronik Miyeloid Lösemi)
Dr. SELİN BERK
KML (Kronik Miyeloid Lösemi)
Hızlı Randevu Al






























